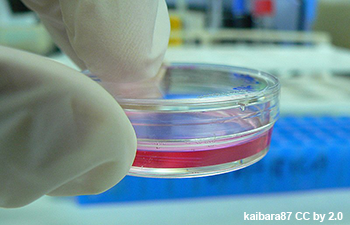
Protein Production, Weizmann Institute, Israel

Protein production in bacteria, baculovirus, and mammalian cells. Proteins are typically purified following a standard 3 step protocol which includes: affinity capture, ion exchange and size exclusion. Specific techniques can be employed depending on the protein, the experimental requirements, tags and yields. Removal of tags with TEV protease can be employed.
Cloning and small scale expression test in E. coli. Cloning or alterations of a gene into a selected vector + small scale expression test with two strains at two temperatures (including small scale affinity capture and analysis by SDS PAGE) The protein production facility is located in the Israel Structural Proteomics Center (ISPC) at the Weizmann Institute of Science. The facility produces proteins in E. coli, baculovirus, 293 cells and Pichia Pastoris.
Cloning and small scale expression test in SF9 and/or High5 cells. Cloning or alterations of a gene into a selected vector + small scale expression test in SF9 and/or High5 cells (including small scale affinity capture and analysis by SDS PAGE) The protein production facility is located in the Israel Structural Proteomics Center (ISPC) at the Weizmann Institute of Science. The facility produces proteins in E. coli, baculovirus, 293 cells and Pichia Pastoris.
Cloning and small scale expression test in HEK293T. Cloning or alterations of a gene into a selected vector + small scale expression test in HEK293T cells (including small scale affinity capture and analysis by SDS PAGE) The protein production facility is located in the Israel Structural Proteomics Center (ISPC) at the Weizmann Institute of Science. The facility produces proteins in E. coli, baculovirus, 293 cells and Pichia Pastoris.
The production of proteins in E.coli, 5L. Proteins are typically purified following a standard 3 step protocol which includes: affinity capture, ion exchange and size exclusion. Specific techniques can be employed depending on the protein, the experimental requirements, tags and yields. Removal of tags with TEV protease can be employed.
The production of proteins both internal and secreted in baculovirus. Proteins are typically purified following a standard 3 step protocol which includes: affinity capture, ion exchange and size exclusion. Specific techniques can be employed depending on the protein, the experimental requirements, tags and yields. Removal of tags with TEV protease can be employed.
The production of proteins in HEK293T, 1.5L. Proteins are typically purified following a standard 3 step protocol which includes: affinity capture, ion exchange and size exclusion. Specific techniques can be employed depending on the protein, the experimental requirements, tags and yields. Removal of tags with TEV protease can be employed.